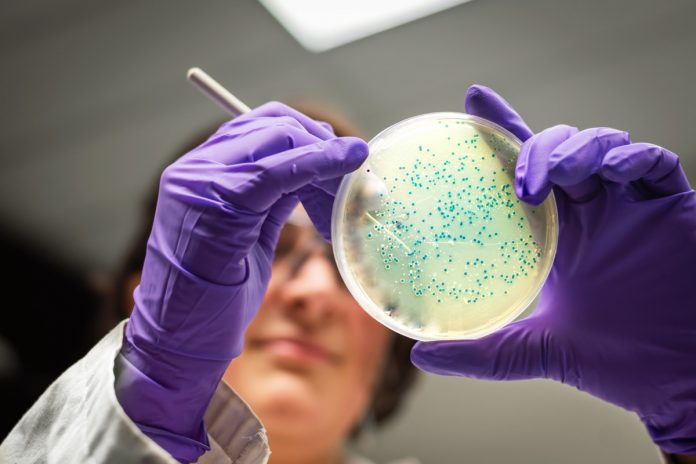

Científicos de la Universidad Federal del Lejano Oriente (FEFU) han identificado en el Mar de Japón bacterias que pueden absorber petróleo a bajas temperaturas. Los resultados del estudio, que se han publicado en las revistas Biologiya Morya y Okeanologiya, podrían sentar las bases para desarrollar un método biológico para eliminar los productos derivados del petróleo del agua de mar.
El estudio se realizó en 50 muestras de aguas superficiales y sedimentos del fondo de la capa superior obtenidas durante expediciones en las partes norte y oeste del Mar de Japón, así como en el Golfo de Pedro el Grande, donde se encuentra el puerto de carga de petróleo de Kozmino y cuatro puertos marítimos. (Vladivostok, Nakhodka, Bolshoy Kamen y Posyet) se encuentran. Las muestras de aguas y sedimentos del fondo se colocaron en un ambiente salino especial con adiciones posteriores de la mezcla de aceite Vityaz, aceite combustible para hornos (con un contenido de azufre del 2,5 %) y aceite diesel de verano. Este entorno se empleó para incubar bacterias oxidantes de hidrocarburos, lo que llevó de 7 a 15 días a la temperatura de 22 grados centígrados y de 15 a 30 días a la temperatura de 5 grados centígrados.
Los científicos encontraron 137 cepas de bacterias en 42 de las 50 muestras analizadas: 49 cepas se recuperaron de los sedimentos del fondo y otras 88 procedían de aguas superficiales. Sin embargo, la capacidad de crecer en un ambiente oleoso se observó en solo 12 cepas, incluidas Paenibacillus ehimensis , Planomicrobium chinense y Mycolicibacterium vanbaalenii. Estos microorganismos demostraron la capacidad de destruir varios compuestos del petróleo a la temperatura de 5 grados centígrados.
“Nuestro estudio se centra en evaluar el potencial metabólico de las bacterias en el Mar de Japón. Identificamos genes responsables de la degradación de ciertos hidrocarburos y comprobamos qué derivados del petróleo pueden utilizar estas bacterias como alimento. En esta etapa de nuestro estudio, nuestro objetivo no es editar el genoma, sino identificar los destructores de aceite natural más activos y luego desarrollar un producto biofarmacéutico para eliminar los contaminantes del petróleo de las aguas del Mar de Japón”, se cita a la participante del proyecto Angelina Medvedeva, como dice FEFU.
Sin embargo, la secuenciación del genoma de las bacterias identificadas permitirá comprender mejor los principios operativos de los genes y las enzimas que contribuyen a la descomposición del petróleo, y facilitará la creación de nuevas tecnologías para monitorear las aguas marinas y eliminar el petróleo y los productos derivados del petróleo. a ellos.